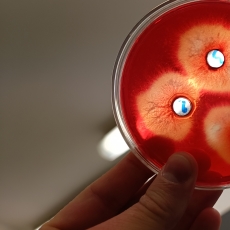

Ostatnie opinie
wystawiono opinii: 2
14 lipca 2024
Serdecznie polecam Pana Pawła. Jego lekcje są doskonale zorganizowane, pełne pasji i zaangażowania. Dzięki jego jasnym i zrozumiałym tłumaczeniom, nawet najbardziej skomplikowane zagadnienia stają się przystępne. Dodatkowo, Pan Paweł udziela wielu cennych wskazówek dotyczących poprawnego pisania odpowiedzi, co znacząco zwiększa szanse na uzyskanie wysokiego wyniku.
9 lipca 2024
Serdecznie polecam korepetycje u Pana Pawła. Każda minuta zajęć jest wykorzystana całkowicie. Po każdym spotkaniu jestem bogatsza o nowe umiejętności i wiedzę. To co wydaje się niemożliwe do zrozumienia nagle okazuje się banalne. Kluczem do dobrze zdanej matury jest bardzo dobre zrozumienie biologii i właśnie tego uczy Pan Paweł.

Wyślij wiadomość